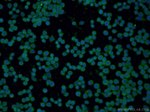
PRDX1 Antibody in Immunocytochemistry (ICC/IF)

Search
Proteintech
PRDX1 Polyclonal Antibody
{{$productOrderCtrl.translations['antibody.pdp.commerceCard.promotion.promotions']}}
{{$productOrderCtrl.translations['antibody.pdp.commerceCard.promotion.viewpromo']}}
{{$productOrderCtrl.translations['antibody.pdp.commerceCard.promotion.promocode']}}: {{promo.promoCode}} {{promo.promoTitle}} {{promo.promoDescription}}. {{$productOrderCtrl.translations['antibody.pdp.commerceCard.promotion.learnmore']}}
产品信息
15816-1-AP
种属反应
已发表种属
宿主/亚型
分类
类型
抗原
偶联物
形式
浓度
规格
纯化类型
保存液
内含物
保存条件
运输条件
产品详细信息
Immunogen sequence: MSSGNAKIG HPAPNFKATA VMPDGQFKDI SLSDYKGKYV VFFFYPLDFT FVCPTEIIAF SDRAEEFKKL NCQVIGASVD SHFCHLAWVN TPKKQGGLGP MNIPLVSDPK RTIAQDYGVL KADEGISFRG LFIIDDKGIL RQITVNDLPV GRSVDETLRL VQAFQFTDKH GEVCPAGWKP GSDTIKPDVQ KSKEYFSKQK (1-199 aa encoded by BC007063)
靶标信息
This gene encodes a member of the peroxiredoxin family of antioxidant enzymes, which reduce hydrogen peroxide and alkyl hydroperoxides. The encoded protein may play an antioxidant protective role in cells, and may contribute to the antiviral activity of CD8(+) T-cells. This protein may have a proliferative effect and play a role in cancer development or progression. Three transcript variants encoding the same protein have been identified for this gene.
仅用于科研。不用于诊断过程。未经明确授权不得转售。
生物信息学
蛋白别名: ACR1; Alu co-repressor 1; AOEB166; B166; epididymis secretory sperm binding protein; HBP23; Heme-binding 23 kDa protein; macrophage 23 Kd stress protein; Macrophage 23 kDa stress protein; macrophage 23kDa stress protein; macrophase stress protein 22kDa; macrophase stress protein 23 kd; Natural killer cell-enhancing factor A; natural killer-enhancing factor A; NKEF-A; OSF-3; osteoblast specific factor 3; Osteoblast-specific factor 3; PAG; Peroxiredoxin-1; PRDX1; proliferation associated gene (pag); proliferation-associated gene A; Proliferation-associated gene protein; Prx; Prx 1; thioredoxin dependent peroxide reductase 2; Thioredoxin peroxidase 2; Thioredoxin-dependent peroxide reductase 2; Thioredoxin-dependent peroxiredoxin 1; Trx dependent peroxide reductase 2; unnamed protein product
基因别名: Hbp23; MSP23; NKEF-A; NKEFA; OSF-3; OSF3; PAG; PAGA; PAGB; PRDX1; PrdxI; PRX1; PRXI; TDPX2; TDX2; TPxA
UniProt ID: (Human) Q06830, (Mouse) P35700, (Rat) Q63716
Entrez Gene ID: (Human) 5052, (Mouse) 18477, (Rat) 117254